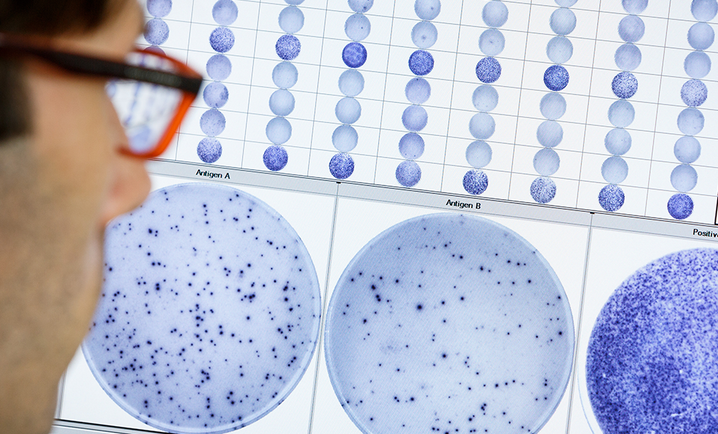
tuberculosis testing services

Oxford Diagnostic Laboratories
Oxford Diagnostic Laboratories (ODL™) is a large referral laboratory for testing services based on the T-SPOT technology using a standardized ELISPOT platform, like the T-SPOT.TB test.
Based in Abingdon, Oxfordshire, our experienced laboratory professionals are committed to providing the highest quality results and service.
Sending patient samples to us could not be easier:
- Collect the blood specimen using a standard heparinized collection tube
- Send to Oxford Diagnostic Laboratories at ambient temperature
- Results are returned 2-3 working days from sample receipt
- Electronic requesting and result reporting is available using the Labgnostic lab-to-lab system, by secure email or via our Web Portal using a secure log in
Contact our customer experience team by requesting more information below or call us at 01235 433164.
Products may not be licensed in accordance with the laws in all countries. Please check with your local representative for availability. Revvity, Inc. does not endorse or make recommendations with respect to research, medication, or treatments. All information presented is for informational purposes only and is not intended as medical advice.
Tuberculosis information
Tuberculosis (TB) is caused by the bacterium Mycobacterium tuberculosis, and can affect any part of the body, but most commonly the lungs (pulmonary).
Only TB of the lung or of the throat can be infectious. This infection is generally transmitted by prolonged and/or frequent contact with an infected person. The bacteria enters the body through the lungs by breathing. It can however travel through the blood and infect other organs leading to non-pulmonary forms of TB.1
A few years ago, TB was thought to be a disease of the past, particularly in the developed world. However, even in the United Kingdom the disease continues to be a significant challenge due to:
- Immunosuppressive conditions (e.g. HIV, immunosuppressive therapy)
- Immigration
- Increasing non-compliance with testing and treatment protocols

The T-SPOT.TB test
The T-SPOT.TB test has demonstrated sensitivity and specificity exceeding 95% and reliability in all patient groups, including the immunosuppressed2, and it does not cross-react with the bacille Calmette-Guerin (BCG) vaccine.
The National Institute of Health and Clinical Excellence (NICE) guidelines give clear recommendations for the use of interferon-gamma release assays (IGRAs) for the detection of tuberculosis in several important patient groups.3
Credentials
At Oxford Diagnostic Laboratories we are committed to providing the highest quality results and service. We are a UKAS accredited testing laboratory under ISO 17025:2017.
Oxford Diagnostic Laboratories operate under Oxford Immunotec’s Quality Management System, which is based on the following International Standards: ISO 17025:2017, ISO 13485:2016 and Medical Device Single Audit Programme (MDSAP) requirements.
IT infrastructure is a key element of our commitment to quality and we have been successfully assessed as meeting the Cyber Essentials implementation profile. Click on ‘Cyber Essentials’ and search for ‘Oxford Immunotec Ltd’ to view the date the certificate was issued.
Suggested content
Screening events
We can provide efficient and effective ways to manage your screening events. We have many years’ experience in organizing and carrying out local screening programs. We undertake screening programs in a variety of locations including workplaces, schools, universities and prisons.
Screening large numbers of people is challenging, and we are highly experienced at organizing such events with our services including:
- Experienced phlebotomists for adult and pediatric sampling taking the required samples for the tests in the programme
- Supply of all consumables including phlebotomy materials and PPE, together with disposal of clinical waste
- Transfer of samples to our laboratory with results returned in various formats
- We can include a coordinator for the screening, both on-site and to assist after the event
Location
Oxford Diagnostic Laboratories operates within Oxford Immunotec Ltd, a Revvity company located in Oxfordshire.
- Oxford Diagnostic Laboratories
- 143 Park Drive
- Milton Park
- Abingdon
- Oxfordshire
- OX14 4SE

Sending samples
Setting up an account
If you are using Oxford Diagnostic Laboratories for the first time, please reach out to our Customer Experience team for assistance in setting up your account. Our dedicated professionals are available Monday to Friday, from 8:30 AM to 4:30 PM GMT, ready to guide you through the process.
You can reach us at 01235 433164 or send us a message
Suggested links:
Sample collection
| Sample type | Whole Blood Lithium Heparin, sodium heparin, and sodium citrate tubes are all acceptable. Samples in any other tube type will be rejected upon receipt as the test will not be able to be performed. |
|---|---|
| Sample volume | Adults: 6 mL Children ≥ 2 to < 10 years: 4 mL Infants < 2 years: 2 mL Please note: The above guidelines may be insufficient in immunocompromised patients with low numbers of PBMCs. Therefore, it may be advisable to collect double the recommended blood volume for immunocompromised patients. |
| Sample storage | Samples should be kept at room temperature prior to despatch (please do not refrigerate). |
| Age of samples on arrival to ODL | Samples must be < 32 hours old, so please send your samples to us on the day of blood collection. The time and date of blood collection must be present on both the tube and the accompanying request form. |
| Address for sending samples | Oxford Diagnostic Laboratories 143 Park Drive Milton Park Abingdon OX14 4SE |
| DX delivery number | DX 654 1400 Abingdon 94 OX |
| Customer queries | If you have any questions, our Customer Experience team is readily available to assist you. You can reach us at 01235 433164 or send us a message. |
Suggested links:
Packaging
Ensure blood sample(s) are securely packaged in a blood transport container complying with IATA packing instructions. Oxford Diagnostic Laboratories can provide further information and appropriate packaging if required.
The request form should be placed in a separate compartment within the packaging. Samples should be stored and transported at ambient temperature and never refrigerated.
Shipping
Ship to arrive at Oxford Diagnostic Laboratories no later than 2.00pm the day after venepuncture.
The request form should be placed in a separate compartment within the packaging. Samples should be stored and transported at ambient temperature and never refrigerated.
Sending by:
- DX: DX is an independent pathology sample courier service which is already established in many NHS hospitals.
Identify the DX exchange location and DX number for your hospital , or search here
If there is no DX box at your location, Oxford Immunotec can assist with a new installation. - DHL: Call Oxford Diagnostic Laboratories on 01235 433164 or send us a message
- Royal Mail: call Oxford Diagnostic Laboratories on 01235 433164 or send us a message.
Interpreting results
You will receive a report which shows an ‘overall result’ along with a clear interpretation.
If you have any questions, our Customer Experience team is readily available to assist you. You can reach us at 01235 433164 or send us a message
Suggested links:
Featured resources
Explore our solutions
References:
- Centers for Disease Control and Prevention. Tuberculosis: Causes and How It Spreads. Available from: https://www.cdc.gov/tb/causes/index.html 2: Mayo Clinic. Tuberculosis - Symptoms & causes. Available from: https://www.mayoclinic.org/diseases-conditions/tuberculosis/symptoms-causes/syc-20351250
- Oxford Immunotec T-SPOT.TB Package Insert PI-TB-IVD-UK-v7. Abingdon, UK. September 2024.
- National Institute for Health and Care Excellence. Tuberculosis. NICE guideline [NG33]. Published: January 13, 2016. Last updated: February 16, 2024. Available from: https://www.nice.org.uk/guidance/ng33

































